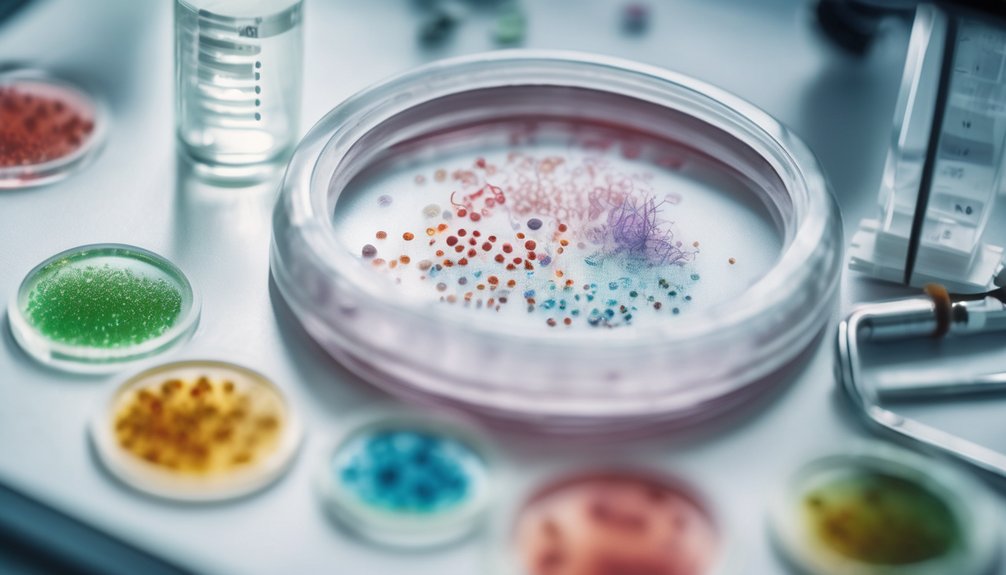
urogenital flora health overview

Resident Alien Season 3: Latest Updates and Episode Outlook
Get ready for surprising twists and deeper mysteries in Resident Alien Season 3 as familiar faces face new challenges that will change everything.
Resident Alien Season 3: Latest Updates and Episode Outlook Read More »